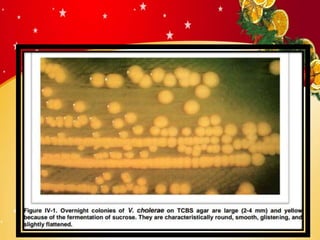

Vibrio cholerae is a serious bacterial disease primarily causing severe diarrhea and dehydration, often spread through contaminated water. While modern sanitation has largely eliminated cholera in many countries, it remains a significant issue in regions affected by war, poverty, and natural disasters. Symptoms include watery diarrhea and vomiting, with treatment focusing on fluid replacement and antibiotics.